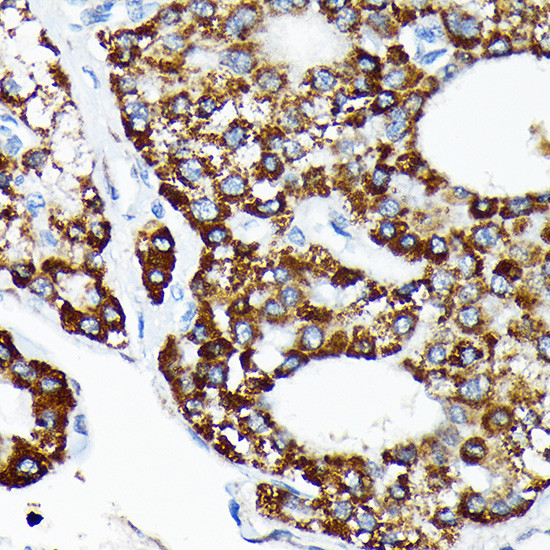
HSPA4 Antibody in Immunohistochemistry (Paraffin) (IHC (P))

Search
Invitrogen
HSPA4 Recombinant Rabbit Monoclonal Antibody (10A9C5)
{{$productOrderCtrl.translations['antibody.pdp.commerceCard.promotion.promotions']}}
{{$productOrderCtrl.translations['antibody.pdp.commerceCard.promotion.viewpromo']}}
{{$productOrderCtrl.translations['antibody.pdp.commerceCard.promotion.promocode']}}: {{promo.promoCode}} {{promo.promoTitle}} {{promo.promoDescription}}. {{$productOrderCtrl.translations['antibody.pdp.commerceCard.promotion.learnmore']}}
图: 1 / 4
HSPA4 Antibody (MA5-37957) in IHC (P)




Please note: We are reviewing Western blot images included in the antibody testing data in our catalog, including those provided by third parties. Unless expressly labeled or annotated as “raw-unedited”, Western blot images included in the antibody testing data in our catalog may have been edited, optimized or otherwise adjusted for presentation.
产品信息
MA5-37957
种属反应
宿主/亚型
Expression System
分类
类型
克隆号
抗原
偶联物
形式
浓度
规格
纯化类型
保存液
内含物
保存条件
运输条件
RRID
产品详细信息
Positive Samples: HeLa, 293T, NIH/3T3, K-562, C6, Mouse testis, Mouse brain, Rat brain
Immunogen sequence: EELGKQIQQY MKIISSFKNK EDQYDHLDAA DMTKVEKSTN EAMEWMNNKL NLQNKQSLTM DPVVKSKEIE AKIKELTSTC SPIISKPKPK VEPPKEEQKN A
靶标信息
The HSP 70 family is composed of four highly conserved proteins: HSP 70, HSC 70, GRP 75 and GRP 78. HSP 70 expression is strongly induced in response to heat stress. HSP 70 and HSC 70 play key roles in the cytosolic endoplasmic reticulum and mitochondrial import machinery and are found in both the cytosol and nucleus of mammalian cells. GRP 78 is localized in the endoplasmic reticulum, where it receives imported secretory proteins and is involved in the folding and translocation of nascent peptide chains. GRP 75 expression is restricted to the mitochondrial matrix and aids in the translocation and folding of nascent polypeptide chains of both nuclear and mitochondrial origin. It has been postulated that members of the HSP 70 family act as force-generating motors, relying on the hydrolysis of ATP for their activity.
仅用于科研。不用于诊断过程。未经明确授权不得转售。
篇参考文献 (0)
生物信息学
蛋白别名: Heat shock 70 kDa protein 4; Heat shock 70-related protein APG-2; Heat shock protein; Heat shock protein family H member 2; heat shock protein, 110 kDa; HSP70RY; Ischemia responsive 94 kDa protein
基因别名: 70kDa; AI317151; APG-2; APG2; Hsp110; Hsp70; Hsp70RY; HSPA4; HSPH2; Irp94; mKIAA4025
UniProt ID: (Rat) O88600
Entrez Gene ID: (Mouse) 15525, (Rat) 266759